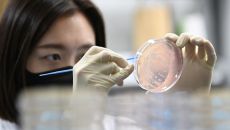
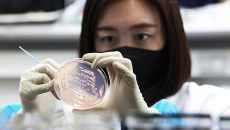

이슈뉴스
-

5월 주식·채권, 외국인이 93억 달러 샀다…2년만 최대치
지난달 외국인 투자자들이 한국 주식과 채권을 90억 달러어치 이상 사들였습니다. 한국은행이 발표한 '국제금융·외환시장 동향'에- 2025.06.13 17:42
- SBS
-

수많은 구설에도 "백종원 지지합니다"…고향 예산에 응원 현수막
위생 문제, 허위 광고 등 잇단 논란으로 방송 중단까지 선언한 백종원 더본코리아 대표를 향해 고향 주민들이 응원 현수막을 걸어- 2025.06.13 17:15
- 머니투데이
-

케이메디허브, DNDi와 함께 '회선사상충증 치료제 개발' 공동 연구 착수
케이메디허브(대구경북첨단의료산업진흥재단)는 글로벌 비영리 국제단체 DNDi(Drugs for Neglected Disease- 2025.06.13 17:06
- 아주경제
-

"더 시원해진" 하동 송림공원 물놀이장 20일 개장
도심 한복판에서 무더위를 날릴 특별한 여름 선물, 하동 송림공원 물놀이장이 오는 20일 개장을 앞두고 있다. 올해 하동군은 기- 2025.06.13 16:18
- 연합뉴스
-

김영록 전남지사, 캄보디아와 보건의료 협력 방안 논의
(무안=연합뉴스) 형민우 기자 = 김영록 전남지사는 13일 캄보디아 프놈펜에서 치앙 라 캄보디아 보건부장관, 렘 다라 캄보디아- 2025.06.13 16:08
- 연합뉴스
-

'풀무원 빵' 집단식중독, 충북 이어 세종·부안까지··· 208명 확인
급식에 제공된 풀무원 계열사 빵을 먹고 발생한 집단식중독이 충북에 이어 세종과 전북 부안군에서도 추가로 확인됐다. 유증상자는- 2025.06.13 15:54
- 서울경제
-

김영록 지사 캄보디아와 보건의료 협력 방안 논의
김영록 전라남도지사는 13일 캄보디아 프놈펜에서 치앙 라 캄보디아 보건부장관, 렘 다라 캄보디아의사회장을 비롯한 고위급인사,- 2025.06.13 15:52
- 아시아경제
-

'의료·요양·돌봄 통합지원' 지자체 31곳 추가…총 131곳 참여
(서울=연합뉴스) 김잔디 기자 = 복지부는 2025년도 제2차 의료·요양·돌봄 통합지원 시범사업에 참여하는 지방자치단체 31곳- 2025.06.13 15:49
- 연합뉴스
-

안양시, 어린이 식생활 안전 뮤지컬 '피터팬이 달라졌어요!' 개최
안양시가 안양시어린이급식관리지원센터(이하 센터) 주관으로 어린이 식생활 안전 뮤지컬을 성황리에 개최했다고 13일 밝혔다. 지난- 2025.06.13 15:16
- 메트로신문사
-

‘89주년’ 가톨릭중앙의료원 “진료·연구·교육 3박자 강화”
가톨릭대학교 가톨릭중앙의료원은 설립 89주년을 맞아 전일(12일) 가톨릭대 옴니버스파크에서 기념식을 열었다고 13일 밝혔다.- 2025.06.13 15:16
- 서울경제
-

군위군, 외식업소 경영혁신 위한 맞춤형 컨설팅 지원
대구 군위군은 '2025년 경영혁신 외식서비스 지원사업'을 본격 추진한다고 11일 밝혔다. 이번 사업은 코로나19 이후 지속되- 2025.06.13 15:10
- 메트로신문사
-

인천시, 가족돌봄청년 집중 발굴…"복지 사각지대 해소"
인천시가 복지 사각지대에 놓인 가족돌봄청(소)년을 집중적으로 발굴해 밀착 지원에 나선다. 가족돌봄청년은 질병, 장애, 고령 등- 2025.06.13 14:59
- 아시아경제
-
KMI한국의학연구소, 고려대의료원에 1억원 기부
고려대의료원은 KMI한국의학연구소로부터 발전기금 1억 원을 전달받았다고 13일 밝혔다. 전일(12일) 서울 성북구 고려대 메디- 2025.06.13 14:58
- 서울경제
-

대한의진균학회 새 회장에 부산백병원 김효진 교수
김효진 인제대 부산백병원 피부과 교수가 최근 열린 ‘제31차 대한의진균학회 학술대회’에서 회장으로 취임했다. 임기는 2025년- 2025.06.13 14:37
- 서울경제
-

“백종원 대표님 지지한다”…예산에 걸린 응원 현수막
[이데일리 이재은 기자] 백종원 더본코리아 대표가 식품표시광고법 위반 등 혐의로 입건된 가운데 그의 고향인 충남 예산지역 이장- 2025.06.13 14:35
- 이데일리
-

풀무원 빵 식중독 확산··· 세종·부안서 추가감염 나오며 유증상자 200명 넘겨
여름철 무더위가 본격적으로 시작되면서 살모넬라균 식중독이 증가 추세다. 특정 빵류 제품을 섭취한 후 발생한 살모넬라균 감염증이- 2025.06.13 13:53
- 경향신문
-

KMI한국의학연구소, 고려대의료원에 1억 원 쾌척
[이데일리 이순용 기자] 고려대학교의료원(의무부총장 겸 의료원장 윤을식)이 KMI한국의학연구소(이사장 이광배, 이하 KMI)로- 2025.06.13 13:32
- 이데일리
-

“1∼1.5kg 이른둥이로 태어나도 97%는 생존”
몸무게 2.5kg 미만 등의 이른둥이는 병원 퇴원 뒤에도 예방접종과 정기 검진을 꼭 받아야 한다는 전문가 권고가 나왔다. 고대- 2025.06.13 13:22
- 한겨레
-

인천시, 가족돌봄청(소)년 집중 발굴…복지 사각지대 해소
13~34세 청(소)년, 누리집 및 청년미래센터 통해 누구나 쉽게 신청 가능 [더팩트ㅣ인천= 김재경 기자] 인천시가 복지 사각- 2025.06.13 13:02
- 더팩트
-

“10대가 돌연 고혈압?…자율신경계 문제일 수도” [병을 이겨내는 사람들]
2021년 11월, 당시 중학교 1학년 김하영 양(16)은 제1차 신종 코로나바이러스 감염증(코로나19) 백신 접종을 마쳤다.- 2025.06.13 13:00
- 동아일보
-

독감 물러갔지만…코로나19, 여름 재유행 우려
지난해 12월 발령된 인플루엔자(독감) 유행주의보가 약 6개월 만에 해제됐다. 질병관리청은 12월 20일 발령했던 2024~2- 2025.06.13 12:20
- 서울신문
-
‘풀무원 빵’ 식중독 확산…세종·부안서 추가 감염 확인
급식으로 나온 빵을 먹고서 집단 식중독에 걸린 사례가 충북에 이어 세종과 전북 부안에서도 추가로 확인됐다. 질병관리청은 최근- 2025.06.13 11:59
- 서울신문
-
유치원부터 태권도장까지…충북서 집단 식중독 잇따라
(청주=연합뉴스) 천경환 기자 = 충북에서 최근 집단 식중독 환자가 잇따라 발생해 주의가 요구된다. 13일 질병관리청 등에 따- 2025.06.13 11:42
- 연합뉴스
-

독감 유행주의보 해제…"여름철 코로나19 감염 주의"
질병관리청은 지난해 12월 20일 발령한 2024-2025절기 인플루엔자(독감) 유행주의보를 오늘(13일)부로 해제한다고 밝혔- 2025.06.13 11:27
- SBS
-
치실·칫솔, 문신용 염료, 이젠 식약처 소관··· 관리체계 강해진다
앞으로 칫솔·치실 등 구강관리용품과 문신용 염료가 식품의약품안전처 소관 품목으로 분류되면서 영업신고, 수입검사 기준, 영업자- 2025.06.13 11:23
- 서울경제



